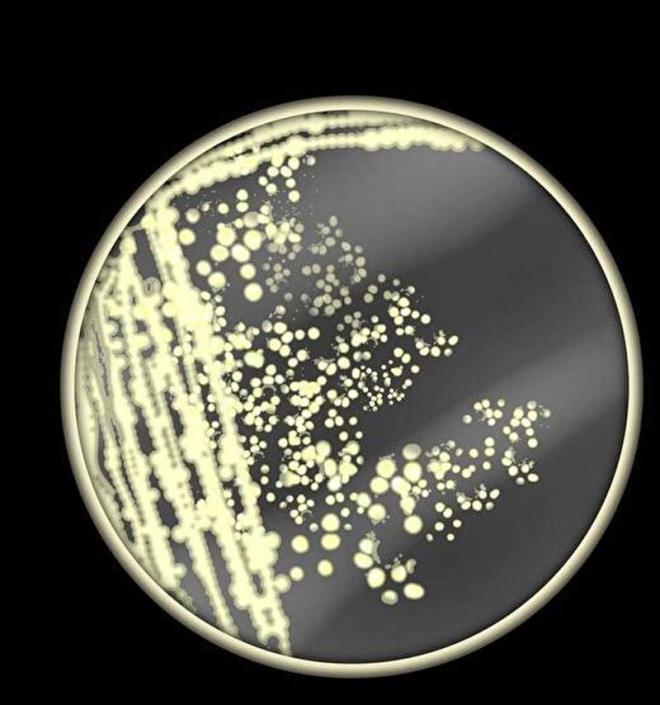
stelik bu enfeksiyonlar corafya ile snrl deil; Birleik Krallk da dahil olmak zere dnyann drt bir yanndaki insanlar giderek gten dren mantar hastalklarna maruz kalyor. Tipik olarak mantarlar, solunum yollarn istila ederek ve beyin de dahil olmak zere sinir sistemine saldrarak ldrr. Baklk sistemleri zayflam kiiler, kanser iin kemoterapi grenler veya HIV/AIDS tedavisi grenler istilac mantar enfeksiyonlar asndan en byk risk altndadr. Raporun yazarlarndan biri olan Haileyesus Getahun, The Telegraph ile yapt zel rportajda, 'Mantar hastalklar, zellikle istilac olanlar giderek daha yaygn hale geliyor ve bunlar zellikle savunmasz, bakl basklanm hastalar etkiliyor' dedi.

Dünyayı Bekleyen Yeni Tehdit Açıklandı!
Dünyayı bekleyen yeni tehdit açıklandı!
-

38 yaşındaki avukat Vikram Trivedi, koronavirüse yakalandığında fazla endişelenmedi. Ancak kısa bir süre sonra sol göz küresi, sinüsünün büyük bir kısmı ve damağı hayatını kurtarabilmek için verilen büyük mücadele sonucunda ameliyatla alındı.
-

Talihsiz adamın hayatını değiştiren ameliyat, Covid-19 ve hatta bakteriyel bir enfeksiyon yüzünden yapılmamıştı. Trivedi'nin bağışıklığı baskılanmış, vücudunu ele geçiren saldırgan bir 'kara mantar' enfeksiyonundan onu kurtarabilmek için doktorların onu başka seçeneği kalmamıştı.
-

2021'de pandeminin ikinci dalgası sırasında Hindistan'da tahminen 4 bin 300 koronavirüs hastası mantar nedeniyle hayatını kaybetti. Halk sağlığıyla ilgili uyarılar tarihsel olarak iki patojen sınıfına odaklanır: Bakteri ve virüsler. Ancak Dünya Sağlık Örgütü'nün (DSÖ) geçtiğimiz gün uyardığı gibi, mantar saldırısının insanlar için oluşturduğu risk hızla artıyor. Artışın sebebinin Covid salgınında ilaçlara direnç geliştiren ve bağışıklığı baskılanmış hastaların sayısının çoğalması olduğu düşünülüyor.
-

DSÖ, en son 2018'de yayınladığı listede 'X Hastalığı' da dahil olmak üzere öncelikli patojenler listesini açıklamıştı. Şimdi ise en tehlikeli 19 mantar türünün yer aldığı liste dünyaya duyuruldu. DSÖ'nün AMR (antimikrobiyal direnç) sorumlusu Dr. Hanan Balkhy "Bakteriyel antimikrobiyal direnç pandemisinin gölgelerinden ortaya çıkan mantar enfeksiyonları büyüyor ve tedavilere her zamankinden daha dirençli hale geliyor, bu da dünya çapında bir halk sağlığı sorunu haline geliyor" dedi. Mantar Enfeksiyonları için Küresel Eylem Fonu, her yıl 300 milyondan fazla insanın ciddi bir mantar enfeksiyonuna yakalandığını ve yılda 1 milyon 600 bin kişinin en yaygın enfeksiyonlardan öldüğünü tahmin ediyor. 25 milyon insanın daha ölme veya görme yetilerini kaybetme riski altında olduğunu söylüyor.
-

Üstelik bu enfeksiyonlar coğrafya ile sınırlı değil; Birleşik Krallık da dahil olmak üzere dünyanın dört bir yanındaki insanlar giderek güçten düşüren mantar hastalıklarına maruz kalıyor. Tipik olarak mantarlar, solunum yollarını istila ederek ve beyin de dahil olmak üzere sinir sistemine saldırarak öldürür. Bağışıklık sistemleri zayıflamış kişiler, kanser için kemoterapi görenler veya HIV/AIDS tedavisi görenler istilacı mantar enfeksiyonları açısından en büyük risk altındadır. Raporun yazarlarından biri olan Haileyesus Getahun, The Telegraph ile yaptığı özel röportajda, 'Mantar hastalıkları, özellikle istilacı olanlar giderek daha yaygın hale geliyor ve bunlar özellikle savunmasız, bağışıklığı baskılanmış hastaları etkiliyor' dedi.
-

Yaşananlarda Covid-19'un da bir rol oynadığına inanılıyor. DSÖ'ye göre, pandemi sırasında hastanede yatan hastalar arasında bildirilen invaziv (yaygın) mantar enfeksiyonlarının zarar verici dokulara dönüşümü 'genellikle yıkıcı sonuçlarla' önemli ölçüde arttı. DSÖ, en endişe verici 19 mantar patojenini, hastalığın halk sağlığı üzerindeki yüküne, antimikrobiyal direncine ve teşhis olanaklarına dayalı olarak kritik, yüksek ve orta öncelikli olmak üzere üç kategoriye ayırdı. Dört kritik patojen, dünyanın dört bir yanındaki ülkelerde bulunur ve çoğunlukla kanser ve organ nakli hastaları gibi bağışıklığı baskılanmış ve kritik hastalığı olan kişilere bulaşıyor.
-

İlk patojen, 'çok ciddi' olarak tanımlanan ve ölüm oranı yüzde 41 ile yüzde 61 arasında değişen cryptococcus neoforman'dır. Toprakta ve çürüyen ahşabın içinde yaşayan ve soluma yoluyla yakalanan patojenik bir mayadır. Akciğerleri etkiler ve ayrıca merkezi sinir sistemine ve kana da yayılabilir. Candida auris, yüksek salgın potansiyeline sahip bir mayadır; şimdiden birkaç hastane salgını ürettiği biliniyor. Ölüm oranı yüzde 29 ile yüzde 53 arasında değişmektedir ve mevcut mantar önleyici ilaçların çoğuna dirençlidir. Bir diğer riskli mantar Aspergillus fumigatus, solunum yoluyla bulaşır. Ağırlıklı olarak akciğer hastalığına neden olur ve beyne yayılabilir. Azole dirençli A. fumigatus enfeksiyonu olanlarda ölüm oranları yüzde 47-88 arasında değişmektedir. Bazı çalışmalarda mortalitenin yüzde 100'e kadar çıktığı bildirilmiştir.
-

Candida albicans ise sağlıklı insan mikrobiyomunun bir parçası olabilir, ancak çoğalırsa veya diğer dokuları istila ederse enfeksiyonlara da neden olabilir. Yüzde 20-50 arasında değişen yüksek mortalite ile hayatı tehdit eden bir hastalık olan invaziv (dokuları bozan) kandidiyazis üretebilir. Listedeki diğer patojenler arasında mucorales, histoplazma spp, cryptococcus gattii ve fusarium spp var.
-

BÜYÜYEN DİRENÇ
Vakalar artsa da şu anda mevcut olan sadece dört antifungal ilaç sınıfı vardır. Dr. Kothalkar, Hindistan'daki mukormikoz (kara mantar) salgını sırasında hastanesinin mantar önleyici tedavileri tedarik etmekte zorlandığını söyledi. "Büyük hasara yol açan bir kıtlık yaşadık" dedi. DSÖ, sınırlı sayıda ilaca karşı direncin de arttığı konusunda uyardı. Kandida oral ve vajinal pamukçuk gibi yaygın enfeksiyonlara neden olan mantarların tedaviye karşı giderek daha dirençli hale geldiği belirtildi.
KÜRESEL UYARI
Hürriyet'in haberine göre, DSÖ, mantar patojenlerinin tedavisi ve gözetiminde araştırma ve geliştirmeye öncelik vermek için küresel bir uyarı yayınladı. Örgüt raporunda "Şu anda Mantar Enfeksiyonları, tüm bulaşıcı hastalık araştırma fonlarının yüzde 1,5'inden daha azını alıyor" diyerek, mantarların gerçek sağlık yükünün bilinmediğini öne sürerken, 'çoğu tedavi kılavuzunun sınırlı kanıt ve uzman görüşü ile bilgilendirildiği' belirtildi.